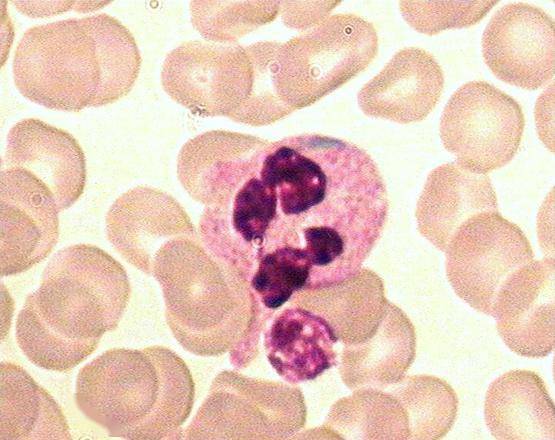
中性粒细胞中含有包涵体,多为云雾状蓝斑,形状多不规则,分布在胞质及

蓝斑核

蓝斑核(神经生物学)_技点科普_技点网(神经生物学)
图片尺寸350x268
大脑,脑干中的蓝斑核
图片尺寸600x450
蓝斑核.ppt.ppt
图片尺寸1152x864
位于脑干的蓝斑核(locus coeruleus ,lc)有许多功能,它影响着一个人的
图片尺寸1000x732
中性粒细胞中含有包涵体,多为云雾状蓝斑,形状多不规则,分布在胞质及
图片尺寸555x440
可能跟大脑里的蓝斑核有关这种现象其实脑科学上有一种解释是找到活命
图片尺寸1080x1067
p>蓝斑核(locus coeruleus),简称蓝斑,亦称青斑核,是位于 a href="#"
图片尺寸3792x2520
【图注】蓝斑核(locus coeruleus)释放多巴胺到大脑各处
图片尺寸640x529
蓝斑是大脑中的一个特定网络,帮助人在压力大或者兴奋时,集中注意力.
图片尺寸540x360
蓝斑核
图片尺寸290x266
蓝斑,图片源自网络
图片尺寸555x555
pnas——蓝斑核释放的多巴胺促进海马依赖的空间学习和记忆能力
图片尺寸571x530
pnas——蓝斑核释放的多巴胺促进海马依赖的空间学习和记忆能力
图片尺寸570x660
4 与惊恐障碍有关的脑区这里所显示的边缘系统的一些区域和蓝斑可能
图片尺寸475x391
把目标锁定在了蓝斑核周围脑区(perilc)的谷氨酸神经元perilcvglut2
图片尺寸538x318
4)参与睡眠发生,抑制痛觉传递 中缝核群中的5-羟色胺能神经元,发出
图片尺寸640x480
现在年轻人为什么经常失眠我们该如何调整和基因有关么
图片尺寸640x455
网友海边拍到神奇生物,全身蓝斑,肛门长在背上喷出紫色墨汁|蓝斑核
图片尺寸668x375
但木星除了大红斑,还有一个大蓝斑,这是一个木星磁场的异常区域,天文
图片尺寸700x467
方略学科导航
图片尺寸1206x508